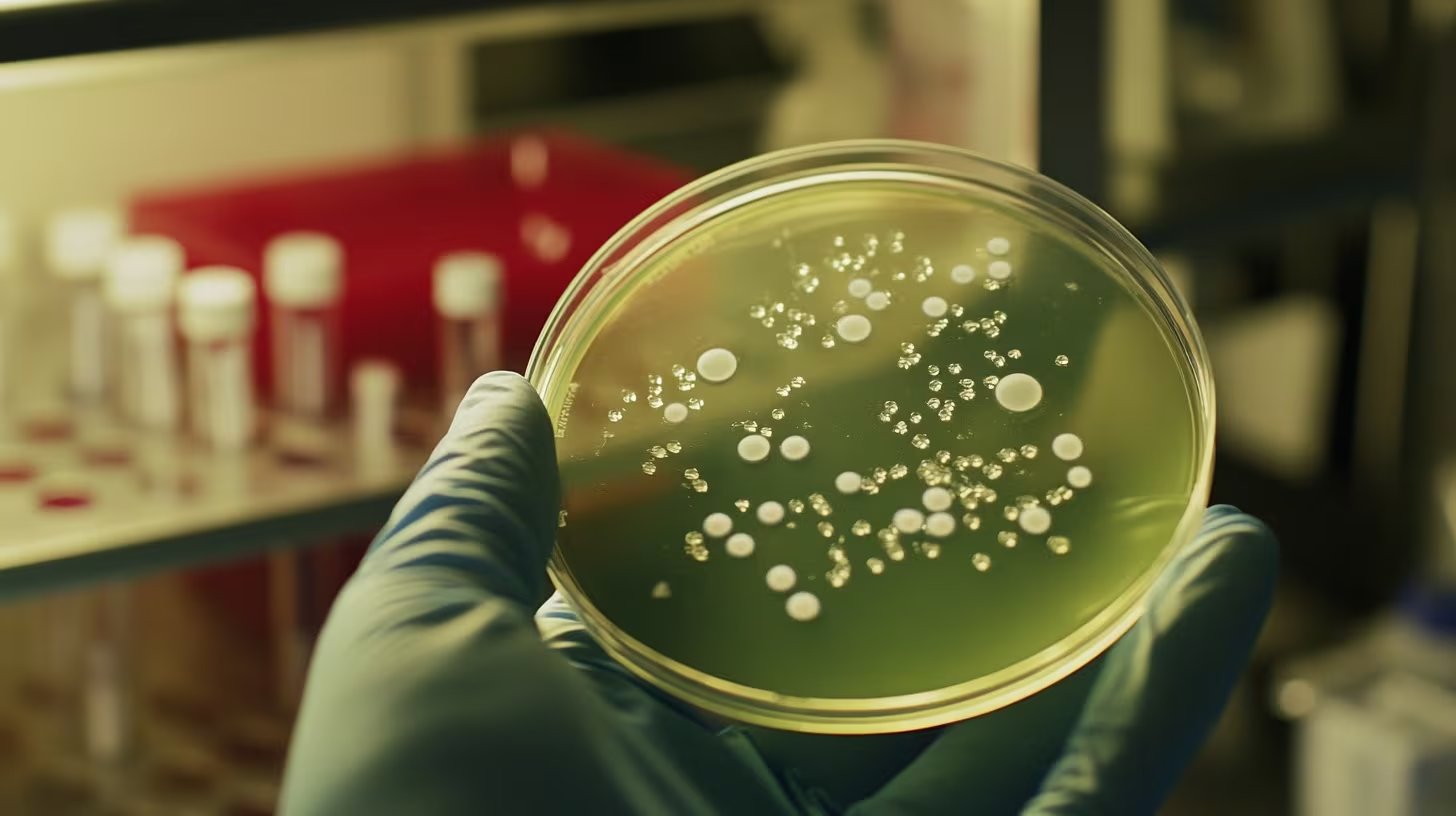
Observaron que quienes tenían más Roseburia inulinivorans exhibieron mejores resultados en pruebas de prensión manual y ejercicios de piernas y banca (Imagen Ilustrativa Infobae)

¿Es posible que un microorganismo alojado en el sistema digestivo sea la clave para preservar la vitalidad física con el paso de los años? Un equipo de especialistas en Europa ha identificado que la bacteria denominada Roseburia inulinivorans podría desempeñar un papel crucial en el mantenimiento del desempeño muscular. Este hallazgo fue recientemente divulgado en Gut, una reconocida publicación científica de alcance internacional.
El estudio se basó en el análisis detallado de muestras biológicas provenientes de ciudadanos residentes en España y los Países Bajos, abarcando distintos rangos etarios. Mediante técnicas avanzadas de secuenciación de ADN de la microbiota, los expertos determinaron que la Roseburia inulinivorans es la única especie que muestra una correlación estadística significativa con un rendimiento superior en evaluaciones de fuerza, tales como la presión manual y ejercicios de resistencia en piernas y banca.
De acuerdo con los datos recopilados, los individuos con una mayor concentración de este microorganismo tendían a registrar niveles de fuerza más elevados, si bien los autores recalcan que este vínculo no establece todavía una relación de causa y efecto directa.
De cara al futuro, la comunidad científica plantea la posibilidad de desarrollar probióticos basados en esta bacteria para mitigar la degradación muscular asociada al envejecimiento. No obstante, el equipo multidisciplinario —integrado por profesionales del Centro Médico Universitario de Leiden, la Universidad de Granada y el Laboratorio Europeo de Biología Molecular de Alemania— advirtió que aún se requieren más evidencias para confirmar su efectividad en la salud cotidiana.
La conexión entre el sistema digestivo y la musculatura

La premisa central de la investigación fue verificar si la composición de la microbiota intestinal influye en la capacidad motriz. Para ello, se conformó un grupo de estudio integrado por 90 jóvenes de entre 18 y 25 años y 33 adultos mayores de más de 65 años.
Las pruebas incluyeron mediciones de consumo máximo de oxígeno y tests de fuerza en diversos grupos musculares. Los resultados arrojaron que, en el grupo de adultos mayores, aquellos que albergaban la bacteria Roseburia inulinivorans presentaban un 29% más de fuerza en la prensión manual en comparación con quienes carecían de ella. Sin embargo, este efecto específico no se tradujo en una mejora de la capacidad de oxigenación en dicho grupo.

En el caso de los sujetos más jóvenes, la abundancia de este microorganismo no solo se vinculó con una mayor potencia física, sino también con una capacidad cardiorrespiratoria optimizada. La investigación también reveló que esta bacteria es más prevalente en la juventud, alcanzando hasta un 6,6% de la microbiota total, mientras que en los adultos mayores su presencia disminuye drásticamente hasta un máximo del 1,3%.
Esta reducción coincide temporalmente con la etapa de la vida en la que suele presentarse la sarcopenia, condición caracterizada por la pérdida progresiva de masa y función muscular.
Evidencias en modelos de laboratorio

Con el fin de profundizar en el impacto de este hallazgo, se realizaron experimentos con modelos animales. Tras someter a ratones a tratamientos antibióticos para reducir su microbiota original, se les administraron diversas especies del género Roseburia. Únicamente los ratones tratados con Roseburia inulinivorans mostraron un incremento del 30% en la fuerza de sus extremidades superiores tras un breve periodo de observación.
A nivel fisiológico, estos ejemplares desarrollaron fibras musculares de mayor tamaño y una mayor proporción de fibras de contracción rápida, esenciales para los movimientos explosivos.

A pesar de estos resultados impactantes, los investigadores señalaron ciertas limitaciones. Las bacterias de origen humano no lograron una colonización permanente en los ratones, lo que sugiere que los beneficios observados podrían ser temporales. Además, factores críticos como la comunicación neuromuscular y los procesos inflamatorios no fueron analizados exhaustivamente en esta fase.
El equipo de investigación concluyó lo siguiente:
“Se necesitan estudios longitudinales para determinar si los cambios en la abundancia de Roseburia inulinivorans son causa o consecuencia de las mejoras en la función muscular”.
Un hallazgo que exige prudencia

Aunque los datos son alentadores, la ciencia mantiene una postura cautelosa. El estudio contó con una muestra reducida y todavía no se han efectuado ensayos clínicos controlados en seres humanos donde se administre la bacteria como tratamiento. Asimismo, variables externas como la alimentación, el nivel de actividad física y el uso de fármacos —que influyen tanto en los músculos como en el intestino— no fueron controladas estrictamente.
Los científicos afirman que la Roseburia inulinivorans se perfila como un modulador específico de la potencia física, sirviendo de puente entre el ecosistema intestinal y el metabolismo del músculo.

La recomendación actual es persistir en la investigación antes de considerar este microorganismo como una solución definitiva. Al respecto, la doctora Silvia Sookoian, investigadora superior del Conicet y decana en la Universidad Maimónides (UMAI), comentó que este trabajo publicado en Gut refuerza la premisa de que ciertas bacterias actúan positivamente en el organismo, vinculándose en este caso con la salud muscular.

Sookoian destacó que algunas especies de Roseburia están bajo estudio como posibles probióticos de nueva generación para tratar afecciones metabólicas y cardiovasculares. No obstante, respecto al estudio específico de la Roseburia inulinivorans, la experta concluyó que
“por el momento sirve más como prueba de concepto que como evidencia robusta de causa-efecto”
debido al tamaño limitado de la muestra y la necesidad de mayor validación en humanos.
Fuente: Fuente

